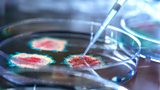

UK DAB/Freeview Schedule
Early
00:00GMT
BBC News—17/06/2021 00:01 GMT
The latest five minute news bulletin from BBC World Service.
00:06GMT
Big Boss Interview—Russia-US summit in Geneva
Biden and Putin praise Geneva summit talks but discord remains
01:00GMT
BBC News—17/06/2021 01:01 GMT
The latest five minute news bulletin from BBC World Service.
01:06GMT
The Newsroom—17/06/2021 01:06 GMT
The world's Newsroom brings you global events as they happen
01:30GMT
BBC News Summary—17/06/2021 01:30 GMT
The latest two minute news summary from BBC World Service.
01:32GMT
Assignment—Syria’s decade of conflict: The many colours of Raqqa
How Syria's secret photographer worked and survived under every force in the conflict
02:00GMT
BBC News—17/06/2021 02:01 GMT
The latest five minute news bulletin from BBC World Service.
02:06GMT
Outlook—We bought the wrong house at auction
Cal and Claire tried to buy a flat, but ended up with a wrecked manor in rural Scotland(R)
02:50GMT
Witness History—The police rape interview that shocked Britain
The documentary that changed the way British police treated women reporting rape.(R)
03:00GMT
BBC News—17/06/2021 03:01 GMT
The latest five minute news bulletin from BBC World Service.
03:06GMT
The Newsroom—17/06/2021 03:06 GMT
The world's Newsroom brings you global events as they happen
03:30GMT
BBC News Summary—17/06/2021 03:30 GMT
The latest two minute news summary from BBC World Service.
03:32GMT
The Food Chain—The school that food built
One headteacher's mission to put food at the heart of all learning
04:00GMT
BBC News—17/06/2021 04:01 GMT
The latest five minute news bulletin from BBC World Service.
04:06GMT
Newsday—Hong Kong police arrest pro-democracy Apple Daily editor
Five senior members of Apple Daily, owned by media mogul Jimmy Lai, have been arrested
05:00GMT
BBC News—17/06/2021 05:01 GMT
The latest five minute news bulletin from BBC World Service.
05:06GMT
Newsday—Raid and arrests of pro-democracy journalists in Hong Kong
Apple Daily, owned by jailed media mogul Jimmy Lai, has been openly critical of China
- Back to top
Morning
06:00GMT
BBC News—17/06/2021 06:01 GMT
The latest five minute news bulletin from BBC World Service.
06:06GMT
Newsday—Arrests at Hong Kong's pro-democracy Apple Daily
Police arrested senior staff on suspicion of violating the national security law
07:00GMT
BBC News—17/06/2021 07:01 GMT
The latest five minute news bulletin from BBC World Service.
07:06GMT
The Inquiry—Could Covid-19 have come from a lab leak?
Kavita Puri explores the theory that the pandemic could have originated in a lab.
07:30GMT
BBC News Summary—17/06/2021 07:30 GMT
The latest two minute news summary from BBC World Service.
07:32GMT
Business Daily—Game over for test cricket?
Do audiences, sponsors and broadcasters still have the patience for five-day matches?
07:50GMT
Witness History—The Trabant
The iconic East German car that dominated the roads of communist Central Europe
08:00GMT
BBC News—17/06/2021 08:01 GMT
The latest five minute news bulletin from BBC World Service.
08:06GMT
Assignment—Syria’s decade of conflict: The many colours of Raqqa
How Syria's secret photographer worked and survived under every force in the conflict(R)
08:30GMT
BBC News Summary—17/06/2021 08:30 GMT
The latest two minute news summary from BBC World Service.
08:32GMT
Health Check—New treatment for Covid
New treatment for Covid; Vaccinating a whole town in Brazil; Protection against Dengue(R)
09:00GMT
BBC News—17/06/2021 09:01 GMT
The latest five minute news bulletin from BBC World Service.
09:06GMT
The Forum—Falconry: The history of hunting with birds of prey
From nomads to nobles, the working relationship between humans and raptors
09:50GMT
Sporting Witness—Football's Coming Home
How England sparked a mood of national euphoria at Euro 96 before it ended in tears
10:00GMT
BBC News—17/06/2021 10:01 GMT
The latest five minute news bulletin from BBC World Service.
10:06GMT
The Newsroom—17/06/2021 10:06 GMT
The world's Newsroom brings you global events as they happen
10:30GMT
BBC News Summary—17/06/2021 10:30 GMT
The latest two minute news summary from BBC World Service.
10:32GMT
The Food Chain—The school that food built
One headteacher's mission to put food at the heart of all learning(R)
11:00GMT
BBC News—17/06/2021 11:01 GMT
The latest five minute news bulletin from BBC World Service.
11:06GMT
Outlook—A top Iranian chess umpire and her impossible decision
Shohreh Bayat was one of Asia’s top chess umpires until she was faced with an ultimatum
11:50GMT
Witness History—The Trabant
The iconic East German car that dominated the roads of communist Central Europe(R)
- Back to top
Afternoon
12:00GMT
BBC News—17/06/2021 12:01 GMT
The latest five minute news bulletin from BBC World Service.
12:06GMT
The Newsroom—17/06/2021 12:06 GMT
The world's Newsroom brings you global events as they happen
12:30GMT
BBC News Summary—17/06/2021 12:30 GMT
The latest two minute news summary from BBC World Service.
12:32GMT
Health Check—New treatment for Covid
New treatment for Covid; Vaccinating a whole town in Brazil; Protection against Dengue(R)
13:00GMT
BBC News—17/06/2021 13:01 GMT
The latest five minute news bulletin from BBC World Service.
13:06GMT
Newshour—Hong Kong cracks down on pro-democracy paper
Police in Hong Kong have raided Apple Daily and arrested senior staff
14:00GMT
BBC News—17/06/2021 14:01 GMT
The latest five minute news bulletin from BBC World Service.
14:06GMT
The Inquiry—Could Covid-19 have come from a lab leak?
Kavita Puri explores the theory that the pandemic could have originated in a lab.(R)
14:30GMT
BBC News Summary—17/06/2021 14:30 GMT
The latest two minute news summary from BBC World Service.
14:32GMT
World Business Report—Arrests at Hong Kong's Apple Daily
Several senior figures have been arrested at Hong Kong's pro-democracy paper Apple Daily
15:00GMT
BBC News—17/06/2021 15:01 GMT
The latest five minute news bulletin from BBC World Service.
15:06GMT
BBC OS—Mandatory vaccinations
We hear from a US nurse who has been suspended from work for refusing a Covid vaccine
16:00GMT
BBC News—17/06/2021 16:01 GMT
The latest five minute news bulletin from BBC World Service.
16:06GMT
BBC OS—OS conversations: Ukraine Iran plane crash
We hear from relatives who lost family members in the Ukrainian plane crash last year
17:00GMT
BBC News—17/06/2021 17:01 GMT
The latest five minute news bulletin from BBC World Service.
17:06GMT
Outlook—A top Iranian chess umpire and her impossible decision
Shohreh Bayat was one of Asia’s top chess umpires until she was faced with an ultimatum(R)
17:50GMT
Witness History—The Trabant
The iconic East German car that dominated the roads of communist Central Europe(R)
- Back to top
Evening
18:00GMT
BBC News—17/06/2021 18:01 GMT
The latest five minute news bulletin from BBC World Service.
18:06GMT
The Newsroom—17/06/2021 18:06 GMT
The world's Newsroom brings you global events as they happen
18:30GMT
BBC News Summary—17/06/2021 18:30 GMT
The latest two minute news summary from BBC World Service.
18:32GMT
Sport Today—2021/06/17 GMT
BBC sports correspondents tell the story behind today's top sporting news, with interviews and reports from across the world.
19:00GMT
BBC News—17/06/2021 19:01 GMT
The latest five minute news bulletin from BBC World Service.
19:06GMT
Assignment—Syria’s decade of conflict: The many colours of Raqqa
How Syria's secret photographer worked and survived under every force in the conflict(R)
19:30GMT
BBC News Summary—17/06/2021 19:30 GMT
The latest two minute news summary from BBC World Service.
19:32GMT
Science In Action—Doubling Earth’s energy imbalance
Nasa scientists find a doubling of our planet’s net solar energy absorption in 15 years
20:00GMT
BBC News—17/06/2021 20:01 GMT
The latest five minute news bulletin from BBC World Service.
20:06GMT
Newshour—First crew blasts off to new China space station
China launches astronauts into orbit for its longest human spaceflight mission
21:00GMT
BBC News—17/06/2021 21:01 GMT
The latest five minute news bulletin from BBC World Service.
21:06GMT
The Inquiry—Could Covid-19 have come from a lab leak?
Kavita Puri explores the theory that the pandemic could have originated in a lab.(R)
21:30GMT
BBC News Summary—17/06/2021 21:30 GMT
The latest two minute news summary from BBC World Service.
21:32GMT
The Food Chain—The school that food built
One headteacher's mission to put food at the heart of all learning(R)
22:00GMT
BBC News—17/06/2021 22:01 GMT
The latest five minute news bulletin from BBC World Service.
22:06GMT
The Newsroom—17/06/2021 22:06 GMT
The world's Newsroom brings you global events as they happen
22:20GMT
Sports News—17/06/2021 GMT
BBC Sport brings you all the latest stories and results from around the world.
22:30GMT
BBC News Summary—17/06/2021 22:30 GMT
The latest two minute news summary from BBC World Service.
22:32GMT
World Business Report—Arrests at Hong Kong's Apple Daily
Several senior figures have been arrested at Hong Kong's pro-democracy paper Apple Daily
23:00GMT
BBC News—17/06/2021 23:01 GMT
The latest five minute news bulletin from BBC World Service.
23:06GMT
The Forum—Falconry: The history of hunting with birds of prey
From nomads to nobles, the working relationship between humans and raptors(R)
23:50GMT
Sporting Witness—Football's Coming Home
How England sparked a mood of national euphoria at Euro 96 before it ended in tears(R)
- Back to top
Late
00:00GMT
BBC News—BBC News
The latest five minute news bulletin from BBC World Service.
00:06GMT
Big Boss Interview—US Supreme Court rejects Trump-backed challenge to Obamacare
Global business news, with live guests and contributions from Asia and the USA.
01:00GMT
BBC News—BBC News
The latest five minute news bulletin from BBC World Service.
01:06GMT
The Newsroom—The Newsroom
The world's Newsroom brings you global events as they happen
01:30GMT
BBC News Summary—BBC News Summary
The latest two minute news summary from BBC World Service.
01:32GMT
World Football—Euro 2020: Ronaldo's records and Eriksen's collapse
We hear from Finland's Tim Sparv, who was on the pitch when Christian Eriksen collapsed.
02:00GMT
BBC News—BBC News
The latest five minute news bulletin from BBC World Service.
02:06GMT
Outlook—A top Iranian chess umpire and her impossible decision
Shohreh Bayat was one of Asia’s top chess umpires until she was faced with an ultimatum(R)
02:50GMT
Witness History—The Trabant
The iconic East German car that dominated the roads of communist Central Europe(R)
03:00GMT
BBC News—BBC News
The latest five minute news bulletin from BBC World Service.
03:06GMT
The Newsroom—The Newsroom
The world's Newsroom brings you global events as they happen
03:30GMT
BBC News Summary—BBC News Summary
The latest two minute news summary from BBC World Service.
03:32GMT
Heart and Soul—Pope Francis in Iraq: The historic pilgrimage
Colm Flynn talks to Iraqi Christians and Muslims who have come out to welcome Pope Francis(R)
04:00GMT
BBC News—BBC News
The latest five minute news bulletin from BBC World Service.
04:06GMT
Newsday—Kenneth Kaunda - the Founding Father of Zambia has died
The former president of Zambia, Kenneth Kaunda was an African liberation struggle giant
05:00GMT
BBC News—BBC News
The latest five minute news bulletin from BBC World Service.
05:06GMT
Newsday—African liberation icon Kenneth Kaunda dies at 97
The first president of independent Zambia has died in Lusaka